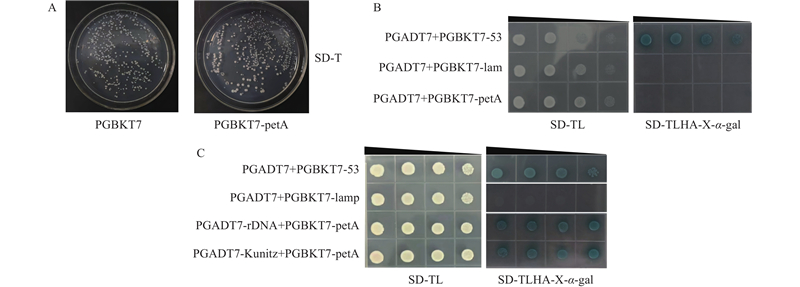

林业科学 ›› 2026, Vol. 62 ›› Issue (4): 178-186.doi: 10.11707/j.1001-7488.LYKX20250391
收稿日期:2025-06-15
出版日期:2026-04-15
发布日期:2026-04-11
通讯作者:
曹传旺
E-mail:chuanwangcao@nefu.edu.cn
基金资助:
Mengyuan Wang,Liu Yang,Lili Sun,Chuanwang Cao*( )
)
Received:2025-06-15
Online:2026-04-15
Published:2026-04-11
Contact:
Chuanwang Cao
E-mail:chuanwangcao@nefu.edu.cn
摘要:
目的: 探究山新杨PdbpetA基因的表达特性和生物学功能,明确该基因在舞毒蛾口腔效应子Armet诱导下激活并调控植株防御反应的分子机制,为深入了解植物抗虫性机制以及抗性育种提供参考。方法: PCR克隆获得山新杨PdbpetA基因完整ORF序列,采用酶切、同源重组等技术将PdbpetA基因序列构建至植物瞬时表达、亚细胞定位和双分子荧光互补载体中,利用瞬时转化系统分析PdbpetA蛋白在烟草细胞中的定位;应用农杆菌介导的植物瞬时转化法获得PdbpetA基因瞬时表达的转基因山新杨,运用实时荧光定量RT-PCR技术检测PdbpetA基因在山新杨中的组织表达特异性,分析对照和转基因山新杨茉莉酸合成相关基因PdbJAR1、PdbAOC和PdbLOX2的相对表达量,通过酵母双杂交系统筛选山新杨PdbpetA的互作蛋白。结果: PdbpetA基因开放阅读框(ORF)长696 bp,编码231个氨基酸,在成熟叶中表达量最高,定位于细胞核和细胞膜中;瞬时过表达山新杨中PdbpetA基因的相对表达量在转化后48 h时达到峰值,瞬时抑制表达山新杨中PdbpetA基因的相对表达量在转化后36 h时被显著抑制;在舞毒蛾幼虫取食的过表达PdbpetA基因山新杨中,PdbJAR1、PdbAOC和PdbLOX2基因的相对表达量均显著上调表达,在瞬时抑制表达PdbpetA的植株中茉莉酸合成基因表达量均显著下降;蛋白互作分析表明,PdbKunitz和PdbrDNA与PdbpetA存在互作关系。结论: 山新杨PdbpetA基因不仅参与植物茉莉酸的合成,同时可能通过与PdbKunitz和PdbrDNA蛋白的相互作用参与植物的防御反应。
中图分类号:
王梦圆,杨柳,孙丽丽,曹传旺. PdbpetA基因响应舞毒蛾Armet诱导调控山新杨防御分子机制[J]. 林业科学, 2026, 62(4): 178-186.
Mengyuan Wang,Liu Yang,Lili Sun,Chuanwang Cao. Molecular Mechanisms of PdbpetA Gene Mediating Defense Responses of Populus davidiana × P. bolleana Induced by Armet in Lymantria dispar[J]. Scientia Silvae Sinicae, 2026, 62(4): 178-186.
表1
所用的引物序列"
| 基因 Gene | 正向引物序列(5'?3') Forward primer sequence | 反向引物序列(5'?3') Reverse primer sequence | 用途 Purpose |
| PdbpetA | ATGCAACTAAAACAAGTTCT | CTAGAAATTCATTTCGG | 目的基因扩增 Target gene amplification |
| Tub | ATGGCATTAAGATTTCCAAGGTT TAGCCAAGG | TTAACCAAATTTGCCCGATGTAG AGGCAATC | 实时荧光定量RT-PCR Quantitative real-time polymerase chain reaction |
| EF1α | GGAAGTGCAGGCTGAGTTG | CACTAAGAAAGAGTATCTGGCCC | |
| Q-PdbpetA | CGGACCCTGCTGCTAAGAAGGA | TTGTTACTCTTGCTCCCGTCGG | |
| Q-PdbLOX2 | GGTGAGAGCTGTGGTGACTGTG | GCTTGCTCCTCCTTGGTTCCTT | |
| Q-PdbAOC | TGGCGACTACGGTCACATTGC | CAAGCAGCTCCTCAGGCAAGT | |
| Q-PdbJAR1 | CTCTTGTGCGGGCTACTCTTCC | GCGGTGACTCTGCTGCTTAGTT | |
| pBI121-PdbpetA-GFP | gactctagactggtacccgggATGCAACTAAA ACAAGTTCTTGCTAAT | atactagtcagtcgacccgggGAAATTCATTT CGGACAATTGAAC | 构建pBI121-GFP载体 Construction of the pBI121-GFP vector |
| pNC-BiFC-Ecn-LdArmet | agtggtctctgtccagtcctATGTATAAATT AGGTGTG | ggtctcagcagaccacaagtCAATTCAGA TTTGCCCA | 构建双分子荧光互补载体 Construction of BiFC vector |
| pNC-BiFC-Enn-PdbpetA | agtggtctctgtccagtcctATGCAACTAAA ACAAGTTC | ggtctcagcagaccacaagtGAAATTCAT TTCGGACAA | |
| PROKII-PdbpetA | gaacacgggggactctagaATGCAACTAAA ACAAGTTCT | gaaattcgagctcggtaccCTAGAAATTCA TTTCGGACA | PdbpetA过表达载体构建 Construction of the PdbpetA overexpression vector |
| PNC-PdbpetA | agtggtctctgtccagtcctATGCAACTAA AACAAGTTCT | ggtctcagcagaccacaagtCTAGAAATT CATTTCGGACA | PdbpetA抑制载体构建 Construction of inhibitory vector for PdbpetA gene |
| PGBKT7-PdbpetA | catggaggccgaattcccgggATGCAACTA AAACAAGTTCT | gcaggtcgacggatccccgggCTAGAA ATTCATTTCGG | PdbpetA酵母载体构建 Construction of the PdbpetA yeast recombinant vector |

图1
PdbpetA基因多序列比对和进化树分析 YP_009764091.1:墨西哥杨Populus mexicana;UFI49286.1:响叶杨Populus adenopoda;YP_009154423.1:欧洲山杨Populus tremula;YP_001109515.1:毛果杨Populus trichocarpa;XBR75516.1:苦杨Populus laurifolia;YP_009054442.1:胡杨Populus euphratica;UFI49371.1:阿富汗杨Populus afghanica;UFI50221.1:缘毛杨Populus ciliata."


图6
PdbpetA蛋白毒性与互作验证 A:诱饵蛋白毒性检测。以转化PGBKT7空载体为对照,检测转入petA蛋白对酵母有无毒性,SD-T:色氨酸酵母缺陷型培养基。Toxicity assay of the bait protein. The yeast strain transformed with the empty PGBKT7 vector served as the control to assess the potential toxicity of the petA protein. SD-T denotes a synthetic dropout medium lacking tryptophan;B:petA蛋白自激活验证。PGADT7+PGBKT7-53/lam分别为阳性与阴性对照,SD-TL:色氨酸、亮氨酸酵母缺陷型培养基,SD-TLHA-X-α-gal:缺少色氨酸、亮氨酸、组氨酸、腺嘌呤同时添加显色底物的酵母培养基。Self-activation verification of the petA protein. PGADT7+PGBKT7-53 and PGADT7+PGBKT7-lam served as the positive and negative controls, respectively. SD-TL represents a synthetic dropout medium lacking tryptophan and leucine, while SD-TLHA-X-α-gal indicates a medium lacking tryptophan, leucine, histidine, and adenine, supplemented with the chromogenic substrate X-α-gal;C:petA、rDNA以及Kunitz蛋白的互作验证。"
|
蔡香云, 王亚如, 姚 杨, 等. 昆虫分泌物介导的昆虫与植物互作研究进展. 昆虫学报, 2024, 67 (2): 284- 306.
doi: 10.16380/j.kcxb.2024.02.013 |
|
|
Cai X Y, Wang Y R, Yao Y, et al. Research progress of the insect secretion-mediated interaction between insects and plants. Acta Entomologica Sinica, 2024, 67 (2): 284- 306.
doi: 10.16380/j.kcxb.2024.02.013 |
|
|
都 慧, 王晓伟, 刘树生. 唾液效应因子BtArmet靶向NtWRKY51调控烟草防御烟粉虱的分子机制. 浙江大学学报(农业与生命科学版), 2022, 48 (6): 753- 760.
doi: 10.3785/j.issn.1008-9209.2022.07.111 |
|
|
Du H, Wang X W, Liu S S. Molecular mechanisms underlying the regulation of tobacco defenses against Bemisia tabaci by the salivary effector BtArmet targeting NtWRKY51. Journal of Zhejiang University (Agriculture and Life Sciences), 2022, 48 (6): 753- 760.
doi: 10.3785/j.issn.1008-9209.2022.07.111 |
|
| 高 源. 2023. 舞毒蛾口腔分泌物及其效应子调控山新杨防御分子机制. 哈尔滨: 东北林业大学. | |
| Gao Y. 2023. Molecular mechanisms of oral secretions in Lymantria dispar and its effector to regulation the defense of Populus davidiana × P. bolleana. Harbin: Northeast Forestry University. [in Chinese] | |
|
李晓芬. 舞毒蛾基本知识及其防治. 现代园艺, 2012, (14): 155.
doi: 10.3969/j.issn.1006-4958.2012.14.136 |
|
|
Li X F. Gypsy moth basic knowledge and its prevention. Contemporary Horticulture, 2012, (14): 155.
doi: 10.3969/j.issn.1006-4958.2012.14.136 |
|
| 王志英, 薛 珍, 范海娟, 等. 转基因白桦对舞毒蛾的抗性研究. 林业科学, 2007, (1): 116- 120. | |
| Wang Z Y, Xue Z, Fan H J, et al. Resistance of transgenic Betula platyphylla to the defoliator Lymantria dispar. Scientia Silvae Sinicae, 2007, (1): 116- 120. | |
|
李 佳, 王 琪, 宫甜甜, 等. rDNA在细胞发育中的转录及调控. 解剖学报, 2018, 49 (5): 695- 698.
doi: 10.16098/j.issn.0529-1356.2018.05.023 |
|
|
Li J, Wang Q, Gong T T, et al. Transcription and regulation of rDNA in cell development. Acta Anatomica Sinica, 2018, 49 (5): 695- 698.
doi: 10.16098/j.issn.0529-1356.2018.05.023 |
|
|
赵孟丹, 张 涛, 刘 艺, 等. 舞毒蛾的危害及防治措施. 现代农村科技, 2021, (12): 39- 40.
doi: 10.3969/j.issn.1674-5329.2021.12.026 |
|
|
Zhao M D, Zhang T, Liu Y, et al. Hazards and prevention measures of Lymantria dispar. Modern Agricultural Science and Technology, 2021, (12): 39- 40.
doi: 10.3969/j.issn.1674-5329.2021.12.026 |
|
| 詹亚光, 王玉成, 王志英, 等. 白桦的遗传转化及转基因植株的抗虫性. 植物生理与分子生物学学报, 2003, (5): 380- 386. | |
| Zhan Y G, Wang Y C, Wang Z Y, et al. Genetic transformation of Betula platyphylla and insect resistance of the transgenic plants. Physiology and Molecular Biology, 2003, (5): 380- 386. | |
|
张洪祥, 陈 倩, 魏太云. 介体昆虫利用唾液蛋白调控植物防御促进自身取食和病毒传播的研究进展. 生命科学, 2025, 37 (5): 514- 521.
doi: 10.13376/j.cbls/2025052 |
|
|
Zhang H X, Chen Q, Wei T Y. Research progress on insect utilizing salivary proteins to regulate plant defenses for promoting vector feeding and viral transmission. Chinese Bulletin of Life Sciences, 2025, 37 (5): 514- 521.
doi: 10.13376/j.cbls/2025052 |
|
| 朱晓南. 2014. 利用酵母双杂交筛选拟南芥细胞色素f相互作用蛋白. 南京: 南京农业大学. | |
| Zhu X N. 2014. Screening of Cyt f interacting proteins by yeast two hybrid in Arabidopsis thaliana. Nanjing: Nanjing Agricultural University. [in Chinese] | |
|
Almeida B R, Meriño-C Y, José S C, et al. Bovine pancreatic trypsin inhibitor and soybean Kunitz trypsin inhibitor: Differential effects on proteases and larval development of the soybean pest Anticarsia gemmatalis (Lepidoptera: Noctuidae). Pesticide Biochemistry and Physiology, 2022, 187, 105188.
doi: 10.1016/j.pestbp.2022.105188 |
|
| Baniulis D, Yamashita E, Zhang H, et al. Structure-function of the cytochrome b6f complex. Photochemistry and Photobiology, 2008, 84 (6): 1349- 1358. | |
|
Bendall D S. The unfinished story of cytochrome f. Photosynthesis Research, 2004, 80 (1/3): 265- 276.
doi: 10.1023/B:PRES.0000030454.23940.f9 |
|
|
Cui N, Lu H, Wang T, et al. Armet, an aphid effector protein, induces pathogen resistance in plants by promoting the accumulation of salicylic acid. Philosophical Transactions of the Royal Society B: Biological Sciences, 2019, 374, 1767.
doi: 10.1098/rstb.2018.0314. |
|
| Divekar P A, Rani V, Majumder S, et al. Protease inhibitors: An induced plant defense mechanism against herbivores. Journal of Plant Growth Regulation, 2023, 42 (10): 6057- 6073. | |
|
Du H, Xu H X, Wang F, et al. Armet from whitefly saliva acts as an effector to suppress plant defenses by targeting tobacco cystatin. The New Phytologist, 2022, 234 (5): 1848- 1862.
doi: 10.1111/nph.18063 |
|
|
Ferreira M M, Santos A S, Santos A S, et al. Plant serpins: potential inhibitors of serine and cysteine proteases with multiple functions. Plants, 2023, 12 (20): 3619.
doi: 10.3390/plants12203619 |
|
|
Hogenhout S A, Bos J I. Effector proteins that modulate plant–insect interactions. Current Opinion in Plant Biology, 2011, 14 (4): 422- 428.
doi: 10.1016/j.pbi.2011.05.003 |
|
| Jagdish M, Koundal K R. Constitutive expression of protease inhibitor gene isolated from black gram (Vigna mungo L. ) confers resistance to Spodoptera litura in transgenic tobacco plants. Indian Journal of Biotechnology, 2020, 19 (2): 94- 101. | |
|
Livak K J, Schmittgen T D. Analysis of relative gene expression data using real-time quantitative PCR and the 2−ΔΔCT method. Methods, 2001, 25 (4): 402- 408.
doi: 10.1006/meth.2001.1262 |
|
|
Ming S C. Inducible direct plant defense against insect herbivores: A review. Insect Science, 2008, 15 (2): 101- 114.
doi: 10.1111/j.1744-7917.2008.00190.x |
|
|
Paes M B, Carpinetti P A, Fraga O T, et al. Abiotic stresses in plants and their markers: a practice view of plant stress responses and programmed cell death mechanisms. Plants, 2022, 11 (9): 110- 0.
doi: 10.3390/plants11091100 |
|
|
Saine G, Carrell C J, Ponamare M V, et al. Interruption of the internal water chain of cytochrome f impairs photosynthetic function. Biochemistry, 2000, 39 (31): 64- 9173.
doi: 10.1021/bi0004596 |
|
|
Santino A, Taurino M, Domenico S, et al. Jasmonate signaling in plant development and defense response to multiple (a)biotic stresses. Plant Cell Reports, 2013, 32 (7): 1085- 1098.
doi: 10.1007/s00299-013-1441-2 |
|
|
Schneider D, Berry S, Rich P, et al. A regulatory role of the PetM subunit in a cyanobacterial cytochrome b6f complex. The Journal of Biological Chemistry, 2001, 276 (20): 780- 16785.
doi: 10.1074/jbc.m009503200 |
|
|
Sun L L, Gao Y, Zhang Q H, et al. Resistance to Lymantria dispar larvae in transgenic poplar plants expressing CYP6B53 double‐stranded RNA. Annals of Applied Biology, 2022, 181 (1): 40- 47.
doi: 10.1111/aab.12752 |
|
| Wasternack C, Strnad M. Jasmonate signaling in plant stress responses and developent active and inactive compounds. New Biotechnology, 2016, 33 (5): 604- 613. | |
|
Wang H J, Zhu X, Li H, et al. Induction of caspase-3-like activity in rice following release of cytochrome-f from the chloroplast and subsequent interaction with the ubiquitin-proteasome system. Scientific Reports, 2014, 4 (1): 5989.
doi: 10.1038/srep05989 |
|
| Wang W, Dai H E, Zhang Y, et al. Armet is an effector protein mediating aphid-plant interactions. The FASEB Journal, 2015, 29 (5): 2032- 2045. | |
|
Xue H, Yan M, Zhu X, et al. AgoArmet and AgoC002: Key effector proteins in cotton aphids host adaptation. Frontiers in Plant Science, 2024, 15, 1500834.
doi: 10.3389/fpls.2024.1500834 |
|
|
Yadav R, Kumar A, Bano N, et al. Co-expression of Cocculus hirsutus trypsin inhibitor with Cry protein reduces resistant development in targeted insects along with complete mortality. Industrial Crops and Products, 2022, 188, 115674.
doi: 10.1016/j.indcrop.2022.115674 |
|
|
Zhao S Y, Chen J H, Cao S F, et al. The regulation of cytochrome f by mannose treatment in broccoli and its relationship with programmed cell death in tobacco BY-2 cells. Plant Physiology and Biochemistry, 2024, 208, 8480.
doi: 10.1016/j.plaphy.2024.108480 |
| [1] | 周凡博,刘玉民,刘亚敏,代崇雯,高琦,张钰林,朱娅婷. 外源茉莉酸甲酯对红椿苗木干旱损伤的缓解作用及生理机制[J]. 林业科学, 2024, 60(12): 58-71. |
| [2] | 韩峭子,陈文文,陈赢男,尹佟明. PdbSPL28基因过量表达提高山新杨对叶斑病的抗性[J]. 林业科学, 2024, 60(10): 56-66. |
| [3] | 牛童非,薛娴,郭丽丽,郁敏,张晨洁,徐鑫傲,李瑞雅,侯小改. 外源茉莉酸甲酯对温室牡丹‘洛阳红’挥发性成分及含量的影响[J]. 林业科学, 2023, 59(5): 53-60. |
| [4] | 马姗姗,杨静静,曲德辉,李梦婕,张进,吴凡林,宿红艳,王磊. 过表达C2H2型锌指蛋白基因PdbZFP26提高山新杨耐盐性[J]. 林业科学, 2023, 59(1): 110-118. |
| [5] | 庄和必,俞子承,林二培,黄华宏. 光皮桦BlBLH1基因的克隆、表达及互作蛋白筛选[J]. 林业科学, 2022, 58(3): 59-68. |
| [6] | 康晓彤,陈辉. 华山松alpha-pinene synthase基因和(-)-limonene synthase基因的克隆及表达[J]. 林业科学, 2021, 57(6): 180-188. |
| [7] | 周心怡,闫丽琼,吕云彤,孙丽丽,朱靖闻,曹传旺. 舞毒蛾取食诱导小黑杨苯丙烷代谢酶活性及其相关基因的表达[J]. 林业科学, 2021, 57(3): 108-116. |
| [8] | 王力敏,陈亚辉,杨庆山,曲日涛,姜姜,张金池,张洪霞,宋志忠. 山新杨钾离子通道基因PdbSKOR的克隆与功能分析[J]. 林业科学, 2021, 57(1): 53-63. |
| [9] | 刘瑞峰,贾桂霞. 水杨酸和茉莉酸/乙烯信号通路关键基因在月季-黑斑病菌互作中的表达模式[J]. 林业科学, 2020, 56(6): 47-58. |
| [10] | 付冰, 叶霞, 王会鱼, 陈鹏, 李继东, 郑先波, 谭彬, 冯建灿. 枣WRKY转录因子的鉴定及其对枣疯病植原体和激素处理的应答[J]. 林业科学, 2018, 54(8): 65-78. |
| [11] | 苑冉, 李欣悦, 吴韶平, 曹传旺. CO2浓度升高对舞毒蛾生长发育和体内解毒酶及保护酶活性的影响[J]. 林业科学, 2018, 54(12): 102-109. |
| [12] | 曾健勇, 张方明, 吴玥, 张婷婷, 张国财. 阿维菌素与杀铃脲对舞毒蛾幼虫的联合作用机制[J]. 林业科学, 2018, 54(12): 110-115. |
| [13] | 姜礅, 薛羿, 徐智文, 王嘉冰, 孟昭军, 严善春. 喷施茉莉酸诱导长白落叶松抗性对舞毒蛾生长发育的影响[J]. 林业科学, 2018, 54(1): 162-167. |
| [14] | 党英侨, 殷晶晶, 陈传佳, 孙丽丽, 刘鹏, 曹传旺. 转舞毒蛾LdCYP6AN15v1基因果蝇品系对氯虫苯甲酰胺胁迫响应[J]. 林业科学, 2017, 53(6): 94-104. |
| [15] | 王晓丽, 李海平, 贾程宇, 段立清. 茉莉酸诱导青杨抗性及核型多角体病毒对舞毒蛾幼虫食物利用的影响[J]. 林业科学, 2016, 52(10): 96-101. |
| 阅读次数 | ||||||
|
全文 |
|
|||||
|
摘要 |
|
|||||